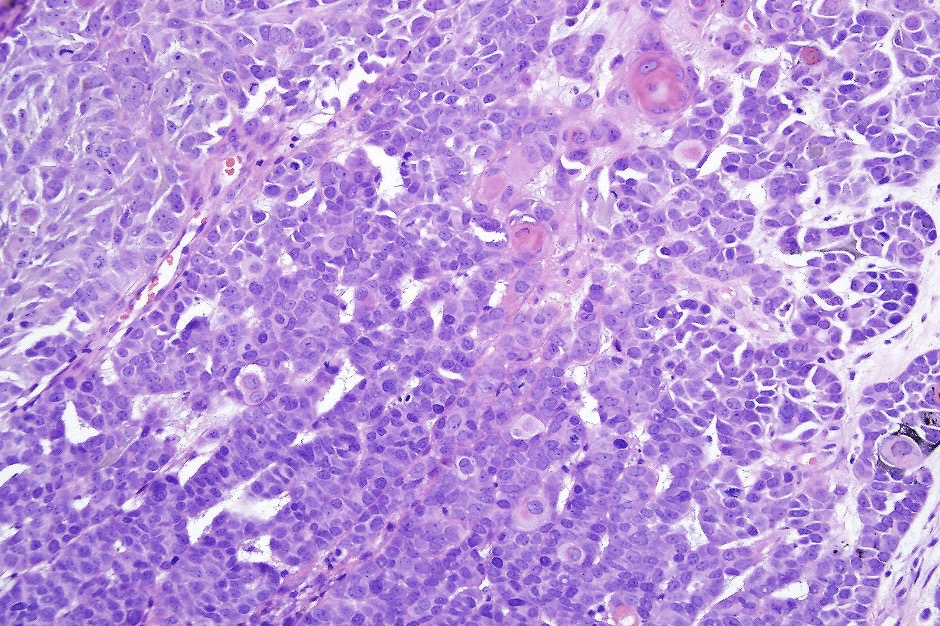
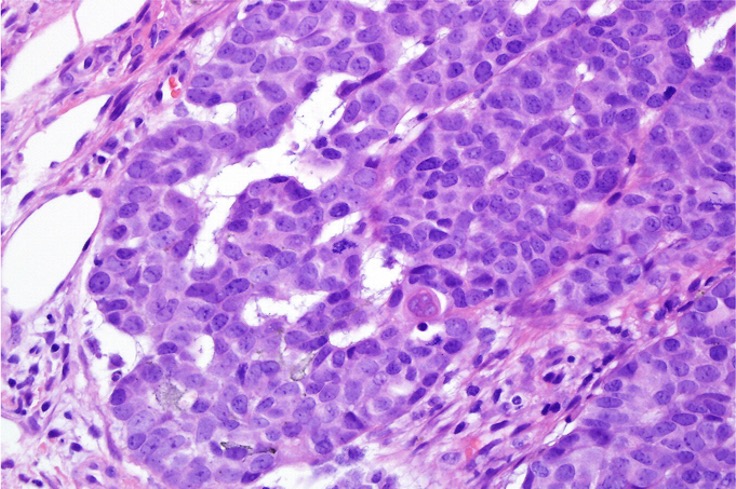
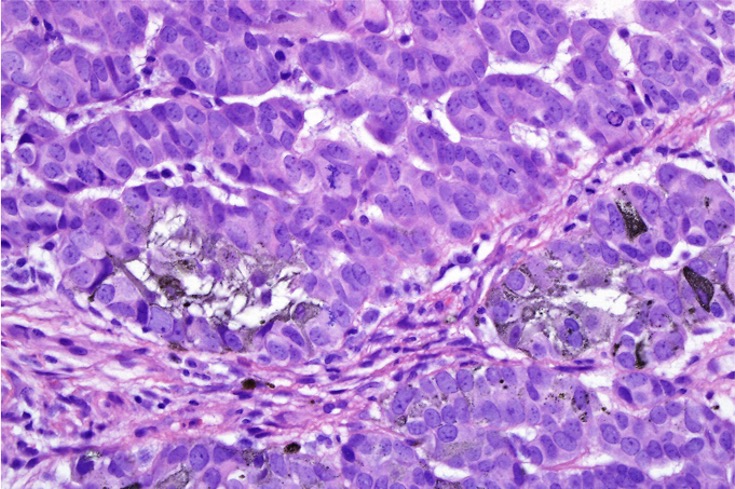
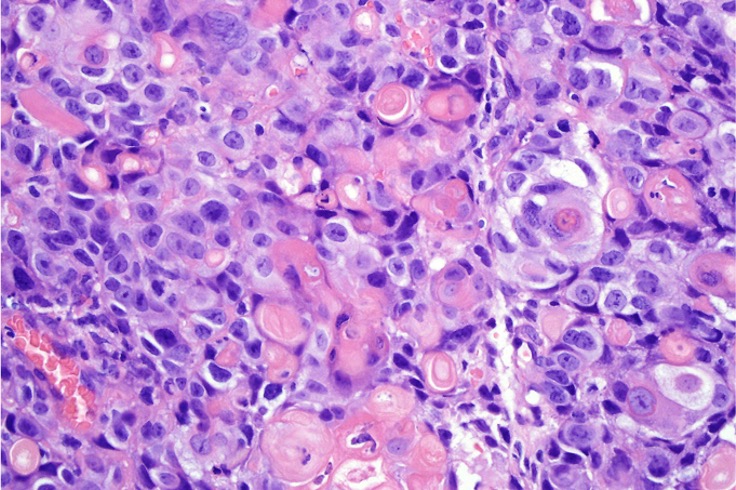
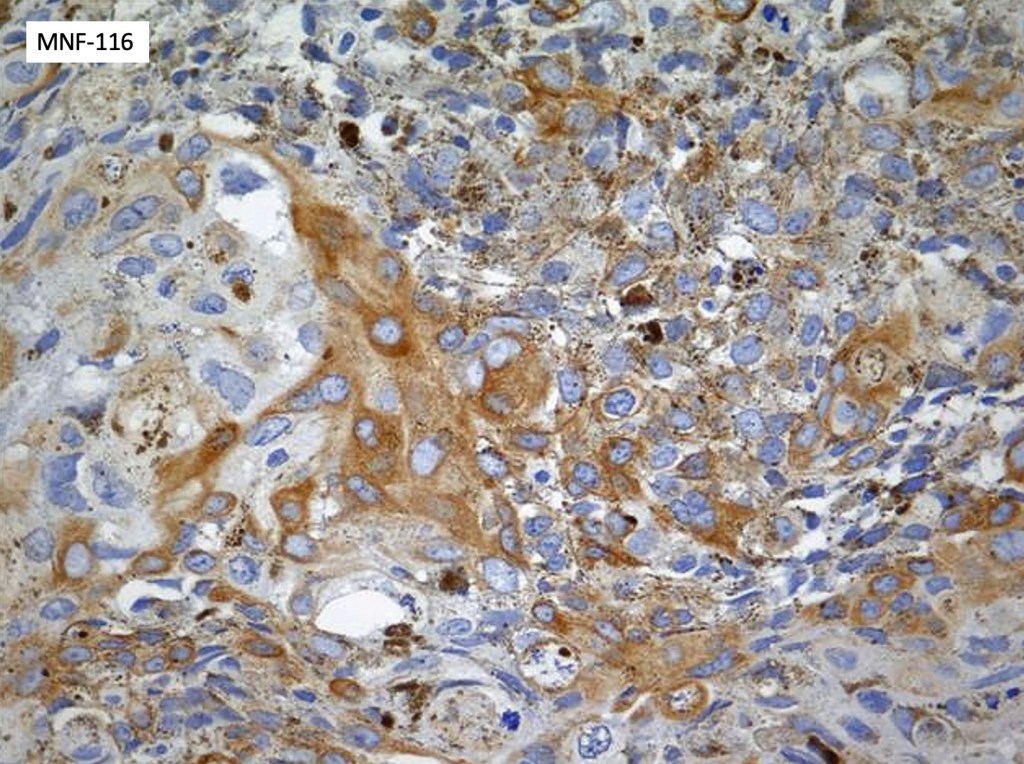

This is a very rare tumor with only 31 cases documented in the literature. It consists of an admixture of matricial cells & usually, heavily pigmented dendritic cells although in some cases, eithelioid melanocytes may also be present.

Clinical features
•Purple-black papulonodule (O.2-2.5 (mean 0.8 cm)
•Elderly (28-92 (median age 70)
•M>F
•Sun damaged skin
•Head & neck>extremities>trunk
•2 cases recurred out of 15 with follow-up
•No evidence of metastasis or mortality in the cases where follow-up is documented
•Additional reports with long term follow-up are required to be confident about the benign nature of this lesion & also its clear distinction from a pigmented variant of matrical carcinoma
Histological features
•Usually well circumscribed
•Nodular or multinodular
•Basaloid population with prominent nucleoli accompanied by supramatricial and ghost cells
•Variable pleomorphism
•Mitoses may be conspicuous
•Heavily pigmented dendritic +/- epithelioid melanocytes
•Basaloid cells show nuclear & cytoplasmic expression of β-catenin
•Dendritic population is enhanced with a Masson Fontana stain
Often solar elastosis is marked

Differential diagnosis
Melanocytic matricoma should be differentiated from pigmented pilomtricoma. This is much nore common and is characterized by pigmented dendritic cells and pigmented matrical cells in the abscence of any mitotic activity or pleomorphism in the melanocytic population. However, there can be considerable overlap.
Dendritic cells are not a feature of matrical carcinoma. Pleomorphism & mitotic activivty is much more pronounced in the latter and perineural infoltration and/or lymphovascular invasion/necrosis may also be present.
In my experience of BCC with matrical differentiation, more obvious features of BCC are invariably present.
Leave a comment